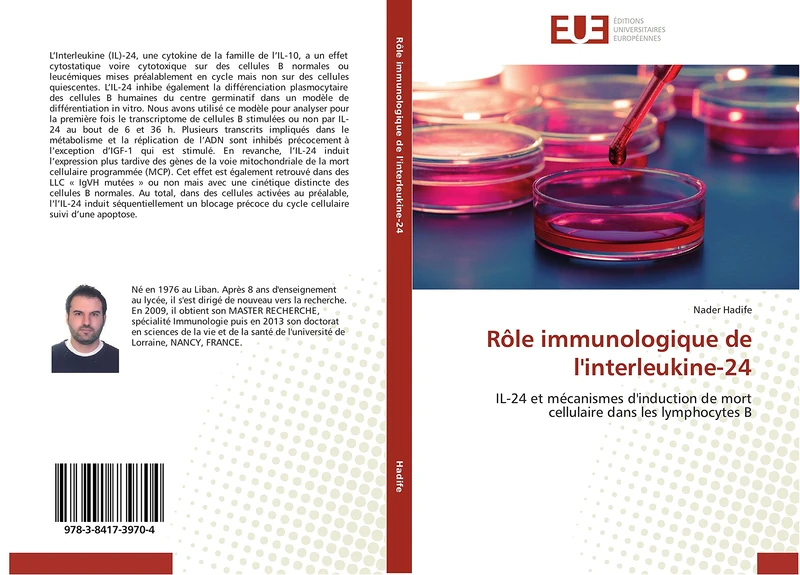
Rôle immunologique de l'interleukine-24: IL-24 et mécanismes d'induction de mort cellulaire dans les lymphocytes B (Omn.Univ.Europ.)

We can't find the internet
Attempting to reconnect
Something went wrong!
Hang in there while we get back on track

£52.00
OmniScriptum Immunité de l'anthrax pulmonaire: Étude des interactions entre les cellules dendritiques pulmonaires murines et Bacillus anthracis (Omn.Univ.Europ.)
Price data last checked 68 day(s) ago - refreshing...
Price History & Forecast
Last 23 days • 23 data points (No recent data available)
Price Distribution
Price distribution over 23 days • 1 price levels
Price Analysis
Most common price: £52 (23 days, 100.0%)
Price range: £52 - £52
Price levels: 1 different prices over 23 days
Product Specifications
- Brand
- OmniScriptum
- Format
- Paperback
- ASIN
- 6131572542
- Domain
- Amazon UK
- Release Date
- 20 May 2011
- Listed Since
- 24 May 2011
Barcode
No barcode data available
Similar Products You Might Like

ANTHROPOLOGIE MOLECULAIRE ET EPIDEMIOLOGIE: INTERACTION ENTRE HAPLOGROUPES ET PATHOLOGIES MITOCHONDRIALES (Omn.Univ.Europ.)
OmniScriptum

Transporteurs ABC de type MDR chez Bacillus subtilis: Rôle et régulation de l'expression de leur gène de structure (Omn.Univ.Europ.)
OmniScriptum

EPIDEMIOLOGIE DESCRIPTIVE DES TUMEURS DANS L'ESPECE FELINE: ETUDE RETROSPECTIVE DANS UN LABORATOIRE D'ANATOMIE PATHOLOGIQUE VETERINAIRE (2000-2007) (Omn.Univ.Europ.)
OmniScriptum

De nouveaux virus chez les Archaea hyperthermophiles marines (Omn.Univ.Europ.)
OmniScriptum
Rôle immunologique de l'interleukine-24: IL-24 et mécanismes d'induction de mort cellulaire dans les lymphocytes B (Omn.Univ.Europ.)
ÉDITIONS UNIVERSITAIRES EUROPÉENNES

Les cellules souches de l’épithélium pulmonaire: Vers de nouvelles approches thérapeutiques (Omn.Pres.Franc.)
OmniScriptum

Pilotage de systèmes de production par des principes immunitaires:: étude de la contribution des systèmes immunitaires artificiels au pilotage de ... en environnement perturbé (Omn.Univ.Europ.)
ÉDITIONS UNIVERSITAIRES EUROPÉENNES

Immunothérapie antitumorale par cellules dendritiques pulsées: Exemple d'une vaccination contre le mélanome avec des cellules dendritiques dérivées de ... hématopoïétiques CD34+ (Omn.Univ.Europ.)
OmniScriptum

Adsorption du Cuivre par le Xanthane: Mécanismes d'adsorption des métaux lourds par les exopolysaccharides bactériens: Le système Xanthane-Cuivre comme modèle d'étude. (Omn.Univ.Europ.)
OmniScriptum

Impact des pollutions agricoles sur les diatomées benthiques: de la communauté d'espèces à la cellule (Omn.Univ.Europ.)
ÉDITIONS UNIVERSITAIRES EUROPÉENNES

Intérêt des peptides natriurétiques dans l'infarctus du myocarde: Etude bibliographique (Omn.Univ.Europ.)
OmniScriptum

Synthèse et activité biologique de nouveaux composés ferrocéniques: Conception, synthèse et activités antiplasmodiale, anti-toxoplasmique et antituberculeuse (Omn.Univ.Europ.)
ÉDITIONS UNIVERSITAIRES EUROPÉENNES

Camptothecines: Mécanisme d'action, apoptose et résistance multiple: Apport des méthodologies à l'interface physique- biologie pour l'étude ... aux camptothécines (Omn.Univ.Europ.)
OmniScriptum

Résistance et diversité génomique de la tuberculose au Cameroun: Une approche épidémiologique moléculaire de la tuberculose pulmonaire (Omn.Pres.Franc.)
OmniScriptum

L'influence de certains aliments sur des fonctions immunitaires: Effets de la lactoferrine, de probiotiques et de sphingolipides sur la souris (Omn.Pres.Franc.)
OmniScriptum

L'apprentissage interculturel au sein de l'université d'entreprise: Une étude de cas (Omn.Univ.Europ.)
OmniScriptum

DEMULTIPLEXAGE OPTIQUE SUBMICRONIQUE-DÉTECTION BIOLOGIQUE PAR PLASMON: MODELISATION-CARACTERISATION DE COMPOSANTS OPTIQUES SUBMICRONIQUES DETECTION ... DE PLASMON DE SURFACE (Omn.Univ.Europ.)
OmniScriptum

Evaluation de la résistance du blé tendre à la rouille brune: Suivi de la virulence du Puccinia triticina et étude de l'hérédité de la résistance du blé tendre à ce parasite (Omn.Univ.Europ.)
OmniScriptum

SYNTHESE ET POLYMERISATION: DE METHACRYLATES PHOSPHONES APPLICATION A L'ANTICORROSION (Omn.Univ.Europ.)
OmniScriptum

Phytochemical study of Launaea arborescens and Halophila stipulacea: Extraction and identification of the isolated compounds from the two species (Omn.Univ.Europ.)
OmniScriptum

Bactéries du sel et Biosurfactants: Entre Isolement, Screening et Production (Omn.Pres.Franc.)
OmniScriptum

RÉGULATION ET ÉVOLUTION QUANTITATIVE D'UN SYSTÈME DE DÉVELOPPEMENT:: LA COMPÉTENCE DES CELLULES PRÉCURSEURS DE LA VULVE CHEZ LES NÉMATODES DU GENRE CAENORHABDITIS (Omn.Univ.Europ.)
OmniScriptum

Molécules en interaction avec des nanoparticules métalliques: sonde optique non linéaire et dynamique femtoseconde de molécules de CO adsorbées sur des nanoparticules épitaxiées (Omn.Univ.Europ.)
OmniScriptum

Évolution des bactériémies nosocomiales à porte d’entrée urinaire: Étude épidémiologique descriptive (Omn.Univ.Europ.)
ÉDITIONS UNIVERSITAIRES EUROPÉENNES